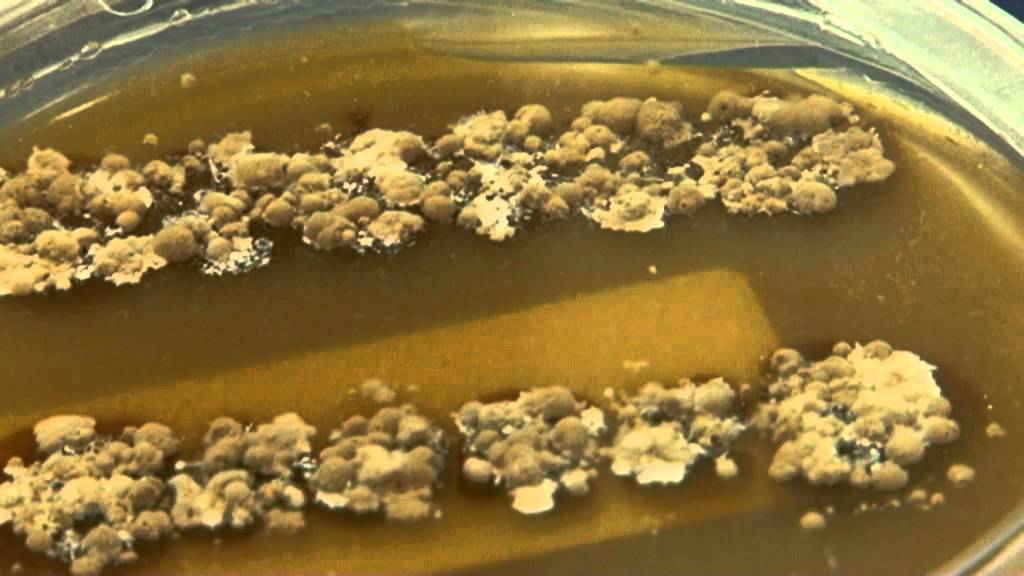
Desarrollo de un fármaco

Desarrollo de un fármaco

Доступные форматы для скачивания:
Скачать видео mp4
-
Информация по загрузке:

PharmaMar - El origen 2025

Grandes farmacéuticas - El poder de las corporaciones | DW Documental

Tecnología aplicada a la biología marina - futuris

OBTENIENDO ACEITE DE COCO

Процедура посева в четырех квадрантах: как правильно засеять чашку Петри для получения изолирован...

Никогда не ешьте грецкие орехи ТАК: Врач объяснил роковую ошибку после 50 лет

Las cuatro fases de la investigación en fármacos

5 операций, которые я, как врач, НИКОГДА бы не сделал! / Вы ПОЖАЛЕЕТЕ об ЭТИХ операциях!
![Мозаика Пенроуза, бесконечная и неповторимая [Veritasium]](https://image.4k-video.ru/id-video/gqlnXRxV32o)
Мозаика Пенроуза, бесконечная и неповторимая [Veritasium]

Versión Completa. El increíble viaje de las plantas. Stefano Mancuso, botánico y profesor

PharmaMar - The Origin 2025

Живая ли Вселенная? | Сквозь кротовую нору с Морганом Фрименом | Discovery

HOMEOPATÍA: ¿Funciona o NO?

¿De dónde vienen los nuevos medicamentos ?

Síntesis de la Aspirina

The origin - english subtitles

¿Cómo hacer un Líquido Fluorescente en CASA? | La Fluorescencia ultravioleta

Просыпаетесь в 3–4 ночи? 5 причин, о которых молчат после 40

El descubrimiento de nuevos fármacos: del laboratorio a la clínica | Roberto Quesada

Cómo se hacen los antibióticos - Laboratorios Bagó